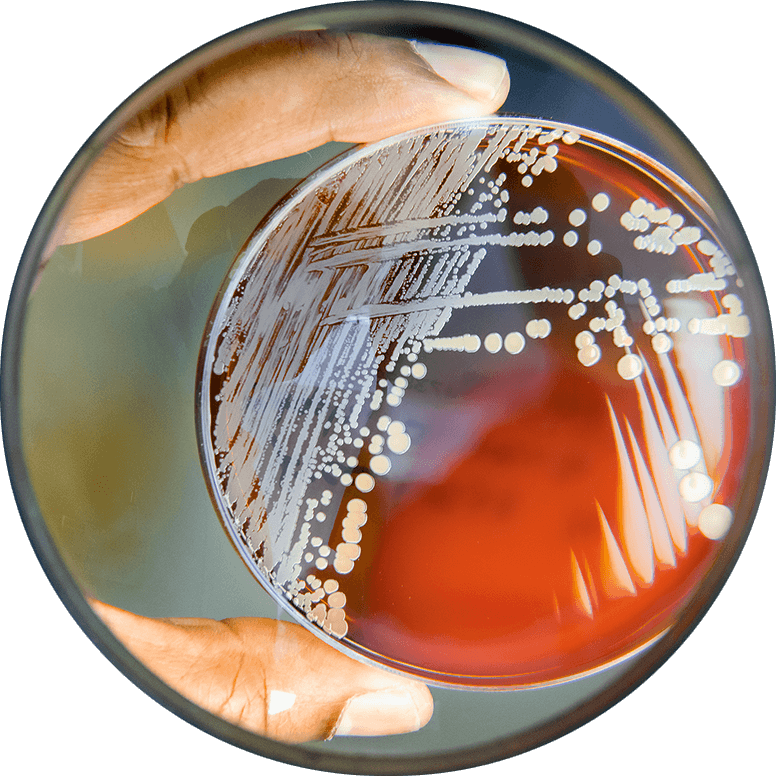
Foto: Nick Neufeld

Puls – Das Magazin für Gesundheitsinteressierte | Ausgabe 04/2022
Diagnostik 4.0: Arbeiten wie die Detektive
Ohne die Unterstützung des Instituts für Mikrobiologie, Infektiologie, Laboratoriumsmedizin und Krankenhaushygiene (MILKy) wäre die erfolgreiche Behandlung von Patientinnen und Patienten nicht möglich. Prof. Dr. Hamid Hossain als neuer Chefarzt erläutert konkrete Aufgaben und Pläne.
Autorin: Prem Lata Gupta

as für eine rätselhafte Patientin! Mit starken Schmerzen war die 78-Jährige ins Klinikum Braunschweig gekommen. Im CT zeigte sich ein Lendenwirbelbruch, der operiert werden musste. Doch die Laborwerte wiesen auch auf eine Infektion hin. Nur wo? Ein Antibiotikum brachte vorübergehend Besserung. Nach der OP verschlechterte sich der Zustand der Frau wieder, sie litt unter Schmerzen und einer lebensgefährlichen Blutvergiftung. Wo steckte bloß der Keim? Diesmal rief die Station das Institut für Mikrobiologie, Infektiologie, Laboratoriumsmedizin und Krankenhaushygiene (MILKy) zu Hilfe. Das MILKy hat vier Abteilungen, drei Standorte und fast 100 hoch spezialisierte Mitarbeitende: Die Fachleute erkannten die lebensbedrohliche Situation, setzten auf spezielle Labordiagnostik, veranlassten ein MRT des Beckens und eine Ultraschalluntersuchung des Herzens. Tatsächlich zeigte sich tief im Beckenmuskel eine Infektion sowie eine infizierte Bandscheibe des Lendenwirbels. Sogar der Schrittmacher war infiziert. Mit der speziellen Labordiagnostik konnte der tief im Körper versteckte Keim auch erkannt werden: Vom Schrittmacher aus hatten sich die Erreger über die Blutbahn ausgebreitet und auch weit entfernte Körperteile geschädigt. In mehreren Schritten wurde der Herzschrittmacher ausgetauscht, die Bandscheibe entfernt und ein Teil der Wirbelsäule stabilisiert. Mit einer spezifischen antibiotischen Therapie konnte die Infektion behandelt werden. Nach einigen Wochen wurde die Patientin geheilt entlassen.
Zur Person
Prof. Dr. Hamid Hossain wurde in Karachi (Pakistan) geboren. Er hat an der Justus-Liebig-Universität in Gießen Humanmedizin studiert und sich anschließend in Mikrobiologie und Infektionsepidemiologie weitergebildet. Wichtige Stationen, bevor er zum 1. April 2022 seine neue Stelle am Klinikum Braunschweig angetreten hat: 2008–2016 Ärztlicher Leiter am Institut für Medizinische Mikrobiologie des Uniklinikums Gießen und Marburg, 2017–2022 Chefarzt Mikrobiologie und Krankenhaushygieniker an den Kliniken Nordoberpfalz AG und am Klinikum St. Marien Amberg, seit 2017 Studiengangskoordinator für Krankenhaushygiene an der Technischen Hochschule Mittelhessen Gießen.
Was für eine rätselhafte Patientin! Mit starken Schmerzen war die 78-Jährige ins Klinikum Braunschweig gekommen. Im CT zeigte sich ein Lendenwirbelbruch, der operiert werden musste. Doch die Laborwerte wiesen auch auf eine Infektion hin. Nur wo? Ein Antibiotikum brachte vorübergehend Besserung. Nach der OP verschlechterte sich der Zustand der Frau wieder, sie litt unter Schmerzen und einer lebensgefährlichen Blutvergiftung. Wo steckte bloß der Keim? Diesmal rief die Station das Institut für Mikrobiologie, Infektiologie, Laboratoriumsmedizin und Krankenhaushygiene (MILKy) zu Hilfe. Das MILKy hat vier Abteilungen, drei Standorte und fast 100 hoch spezialisierte Mitarbeitende: Die Fachleute erkannten die lebensbedrohliche Situation, setzten auf spezielle Labordiagnostik, veranlassten ein MRT des Beckens und eine Ultraschalluntersuchung des Herzens. Tatsächlich zeigte sich tief im Beckenmuskel eine Infektion sowie eine infizierte Bandscheibe des Lendenwirbels. Sogar der Schrittmacher war infiziert. Mit der speziellen Labordiagnostik konnte der tief im Körper versteckte Keim auch erkannt werden: Vom Schrittmacher aus hatten sich die Erreger über die Blutbahn ausgebreitet und auch weit entfernte Körperteile geschädigt. In mehreren Schritten wurde der Herzschrittmacher ausgetauscht, die Bandscheibe entfernt und ein Teil der Wirbelsäule stabilisiert. Mit einer spezifischen antibiotischen Therapie konnte die Infektion behandelt werden. Nach einigen Wochen wurde die Patientin geheilt entlassen

oder gar mehr aller Behandlungsfälle
werden bei der Diagnosefindung durch
Labordiagnostik unterstützt.
oder gar mehr aller Behandlungsfälle werden bei der Diagnosefindung durch Labordiagnostik unterstützt.
Jedes Detailergebnis ist wie ein Puzzleteil
Es ist nur eine Erfolgsgeschichte von vielen, die Prof. Dr. Hamid Hossain, neuer Chefarzt des MILKy, erzählen kann. Plastisch beschreibt er seine Arbeit: „Unser Institut unterstützt mit Diagnostik und Therapie bei allen Krankheiten – von A wie Arthritis über H wie Herzinfarkt bis Z wie Zeckenbiss. Ein Tumor, der beispielsweise durch CT oder MRT noch nicht sichtbar ist, lässt sich durch Labormarker im Blut nachweisen. Wir untersuchen Blut, Urin, Stuhl, Gewebe, Abstriche und sogar Haare und Fingernägel auf krankhafte Veränderungen. Die Ergebnisse sind wie Puzzleteile, die zusammen das Bild einer Erkrankung ergeben.“ Er ist Facharzt für Mikrobiologie, Krankenhaushygieniker und ein sogenannter Antibiotic-Stewardship-Experte: Dieser berät Ärztinnen und Ärzte, ob und welche Antibiotika eingesetzt werden sollten. Und weil selbst Medizinerinnen und Mediziner teilweise unsicher sind bei der Behandlung von komplexen Infektionen oder im Umgang mit multiresistenten Keimen, plant Prof. Hossain, neben der Beratung auf Station auch digitale Visiten einzuführen. „Bei diesen regelmäßigen Videokonferenzen können standortunabhängig Fälle vorgestellt werden. Mein Team empfiehlt dann die Diagnostik und Therapie.“
In seinen Verantwortungsbereich fällt auch die Krankenhaushygiene. Er erklärt: „Wir leben in einer Welt voller Keime, der Mensch selbst ist ein bakterieller Superorganismus.“ So sei es möglich, dass bei einer Operation trotz Hautdesinfektion die eigenen Hautbakterien des Patienten oder der Patientin zu einer Infektion führen. „Unser Ziel ist es, Maßnahmen zur Infektionsverhütung vorzugeben und deren Einhaltung zu überprüfen. Wir schützen Patientinnen, Patienten und Personal, wo wir nur können. Dabei orientieren wir uns an nationalen und internationalen Standards.“


Dr. Hamid Hossain
Chefarzt des Instituts für Mikrobiologie, Infektiologie, Laboratoriumsmedizin und Krankenhaushygiene

Gruppenbild mit Chefarzt: Alle Kolleginnen und Kollegen hätten nicht aufs Foto gepasst. Denn das Institut hat beinahe 100 Mitarbeitende.
Neues Diagnostikzentrum
Aktuell geht es dem neuen Chef des MILKy um eine Weiterentwicklung und Profilierung der Labordiagnostik. „Wir werden vollautomatische Laborstraßen mit Robotern und künstlicher Intelligenz einsetzen – Tag und Nacht. So können wir hochwertige Ergebnisse um etliche Stunden beschleunigen. Das ist Diagnostik 4.0 – sie kommt Patientinnen und Patienten zugute.“ Weiteres wichtiges Ziel ist die Gründung eines Diagnostikzentrums: Dabei sollen das Klinikum Braunschweig und das Klinikum Wolfsburg kooperieren. Eine entsprechende Vereinbarung wurde von den Stadtoberhäuptern unterzeichnet. „Die Kliniken wollen angesichts der großen Herausforderungen der kommenden Jahre noch besser zusammenarbeiten“, bestätigte Braunschweigs Oberbürgermeister Dr. Thorsten Kornblum. Auch der Ärztliche Direktor des Klinikums Braunschweig, Dr. Thomas Bartkiewicz, sieht ein gemeinsames Diagnostikzentrum als zeitgemäßen Schritt: „Das Thema Fachkräftemangel macht einen Zusammenschluss notwendig. Wir realisieren Qualitätssicherung durch Zentralisierung. Außerdem sind wir noch wirtschaftlicher.“

Dr. Thomas Bartkiewicz, Ärztlicher Direktor, und Dr. Wolfgang Eberl (rechts) sehen Vorteile in dem geplanten Diagnostikzentrum.
Aktuell geht es dem neuen Chef des MILKy um eine Weiterentwicklung und Profilierung der Labordiagnostik. „Wir werden vollautomatische Laborstraßen mit Robotern und künstlicher Intelligenz einsetzen – Tag und Nacht. So können wir hochwertige Ergebnisse um etliche Stunden beschleunigen. Das ist Diagnostik 4.0 – sie kommt Patientinnen und Patienten zugute.“ Weiteres wichtiges Ziel ist die Gründung eines Diagnostikzentrums: Dabei sollen das Klinikum Braunschweig und das Klinikum Wolfsburg kooperieren. Eine entsprechende Vereinbarung wurde von den Stadtoberhäuptern unterzeichnet. „Die Kliniken wollen angesichts der großen Herausforderungen der kommenden Jahre noch besser zusammenarbeiten“, bestätigte Braunschweigs Oberbürgermeister Dr. Thorsten Kornblum. Auch der Ärztliche Direktor des Klinikums Braunschweig, Dr. Thomas Bartkiewicz, sieht ein gemeinsames Diagnostikzentrum als zeitgemäßen Schritt: „Das Thema Fachkräftemangel macht einen Zusammenschluss notwendig. Wir realisieren Qualitätssicherung durch Zentralisierung. Außerdem sind wir noch wirtschaftlicher.“
In dem neuen Diagnostikzentrum sollen auch Pathologie, Transfusionsmedizin und der Blutspendedienst untergebracht werden. Vor allem aber wird dort der größte Teil der Labordiagnostik stattfinden. „Ich erwarte eine Verbesserung der Abläufe, was Probenentnahme und -transport als auch qualifizierte Befundung und das Leistungsspektrum anbetrifft. Das Klinikum hat die Möglichkeit, die hier zur Verfügung stehenden hoch qualifizierten Untersuchungen und die dazugehörigen Fachleute für umliegende Krankenhäuser sowie niedergelassene Kolleginnen und Kollegen nutzbar zu machen“, erklärt Dr. Wolfgang Eberl, der auf pädiatrische Onkologie und Hämatologie spezialisiert und Leiter eines klinikeigenen Speziallabors für Blutgerinnungsuntersuchungen ist.
Wichtige Rolle in Pandemiezeiten
In nächster Zukunft wird das MILKy angesichts steigender Infektionszahlen auch in Sachen Corona stark gefordert sein. Prof. Hossain: „Was Covid angeht, spielen wir eine sehr wichtige Rolle. Unsere Labordiagnostik erkennt Covid-Patientinnen und -Patienten. Unsere hygienischen Vorgaben regeln das weitere Vorgehen.“ Sein Ziel lautet: „Wir wollen Infizierte noch früher erkennen.“ Der Chefarzt will die Expertise auch hinsichtlich molekularer Diagnostik ausbauen. Er selbst kommt aus der Genomforschung und erklärt: „Jede erkrankte Zelle und jeder Erreger ist einzigartig wie ein Fingerabdruck.“ Molekulare Diagnostik kann Ursachenfindung und gezielte Behandlung verbessern und erleichtern.
Die ältere Dame jedenfalls, bei der die MILKy-Spezialisten den Herzschrittmacher als „Verteilzentrum“ für den schädlichen Keim identifizierten, zeigte sich nach geglückter Therapie höchst erfreut: „Ich bin froh, dass es die Keimdetektive im Klinikum gibt. Ich hätte sonst nicht überlebt.“
